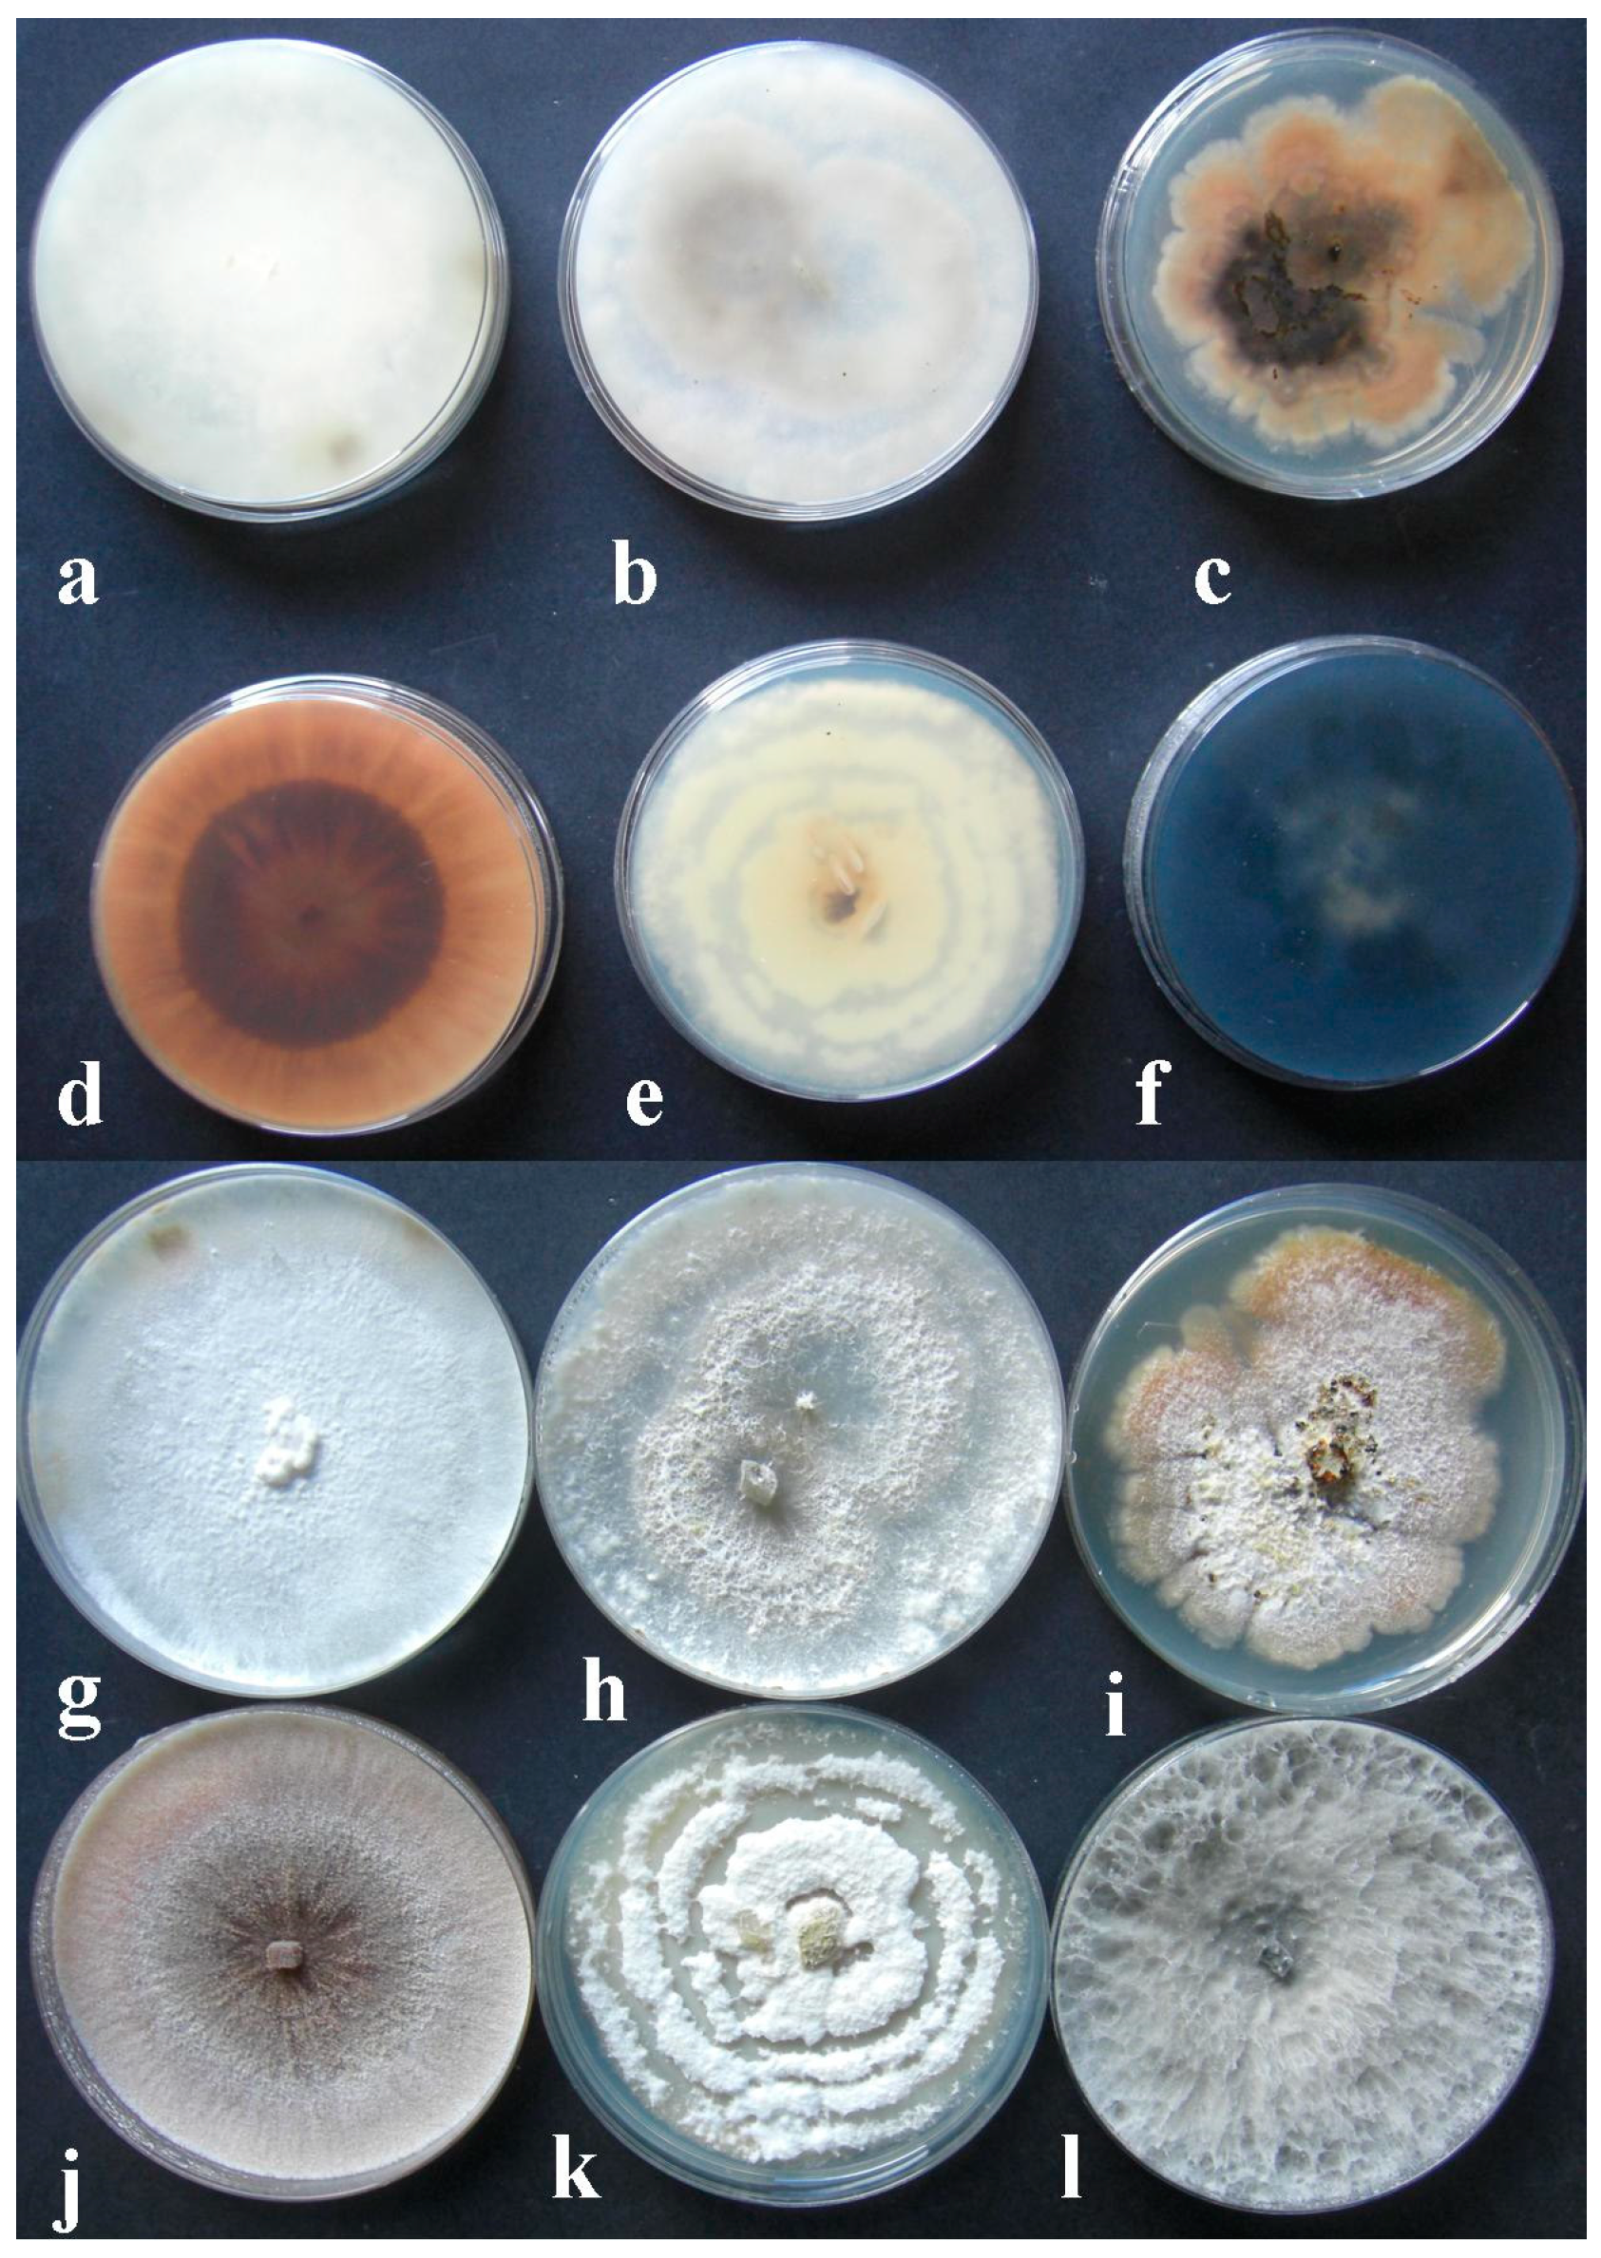
Plants 11 01374 g001 Plants 11 01374 g001

Investigations on Fungi Isolated from Apple Trees with Die-Back Symptoms from Basilicata Region (Southern Italy)
Abstract
1. Introduction
2. Results
2.1. Pathogens Isolations
2.2. Morphological Identification
2.3. Molecular Characterization
2.4. Phylogenetic Analysis
2.5. Pathogenicity Trial
3. Discussion
4. Materials and Methods
4.1. Biologic Material
4.2. Pathogen Isolation
4.3. Morphological Identification
4.4. Molecular Characterization
4.5. Sequences Alignments and Phylogenetic Analysis
4.6. Pathogenicity Trials
4.7. Statistical Analysis
5. Conclusions
Supplementary Materials
Author Contributions
Funding
Institutional Review Board Statement
Informed Consent Statement
Data Availability Statement
Acknowledgments
Conflicts of Interest
References
- Doepel, R.F. Wood-rotting fungi associated with dieback in apple trees: Progress report: Orchard surveys and laboratory studies. J. Dep. Agric. West. Aust. 1962, 3, 668–678. Available online: https://researchlibrary.agric.wa.gov.au/journal_agriculture4/vol3/iss9/2 (accessed on 15 January 2022).
- Jeffers, S.N.; Aldwinckle, H.S.; Burr, T.J.; Arnerson, P.A. Phytophthora and Phytium species associated with crown rot in New York apple orchards. Phytopathology 1982, 72, 533–538. [Google Scholar] [CrossRef]
- Latorre, B.A.; Rioja, M.E.; Wilcox, W.F. Phytophthora species associated with crown rot of apple in Chile. Plant Dis. 2001, 85, 603–605. [Google Scholar] [CrossRef] [PubMed]
- Mazzola, M.; Andrews, P.K.; Reganold, J.P.; Lévesque, A. Frequency, virulence, and metalaxyl sensitivity of Phytium spp. isolated from apple roots under conventional and organic production systems. Plant Dis. 2002, 86, 669–674. [Google Scholar] [CrossRef] [PubMed]
- Di Francesco, A.; Rusin, C.; Di Foggia, M.; Marceddu, S.; Rombolà, A.; Botelho, R.V.; Baraldi, E. Characterization of apples cultivars susceptibility to Neofusicoccum parvum Brazilian strains. Eur. J. Plant Pathol. 2020, 156, 939–951. [Google Scholar] [CrossRef]
- Cloete, M.; Fourie, P.H.; Damm, U.; Crous, P.W.; Moster, L. Fungi associated with die-back symptoms of apple and pear trees, a possible inoculum source of grapevine trunk disease pathogens. Phytopathol. Mediterr. 2011, 50, S176–S190. [Google Scholar] [CrossRef]
- Souli, M.; Paloma, A.-C.; Prez-Sierra, A.; Fattouch, S.; Armengol, J.; Boughalleb, N. Etiology of apple tree dieback in Tunisia and abiotic factors associated with the disease. Afric. J. Microbiol. Res. 2014, 8, 2272–2281. [Google Scholar] [CrossRef][Green Version]
- ISTAT 2019. Coltivazioni Legnose Fruttifere. Available online: http://dati.istat.it (accessed on 15 January 2022).
- Lindner, L. Analisi diagnostiche. In Diagnostica Fitopatologica. Relazioni D’attività anni 2014–2006. Centro di Sperimentazione Laimburg, Bolzano (BZ), 77 Pag. (Diagnostic Analyses. Phytopathology Diagnostic. Activity Reports Years 2012–2006; Experimental Center Laimburg: Bolzano, Italy, 2014; 77p. [Google Scholar]
- Prodorutti, D.; Cainelli, C.; Gualandri, V.; Profaizer, D.; Dallago, G.; Branz, A.; Deliati, I.; Pertot, I.; Angeli, G. Moria e deperimento del melo in Trentino. Atti Giornate Fitopatol. 2012, 2, 619–621. [Google Scholar]
- Kienholz, J.R. Comparative study of the apple anthracnose and perennial canker fungi. J. Agric. Res. 1939, 59, 635–665. [Google Scholar]
- Pennycook, S.R.; Samuels, G.J. Botryosphaeria and Fusicoccum species associated with ripe fruit rot of Actinidia deliciosa (Kiwifruit) in New Zealand. Mycotaxon 1985, 24, 445–458. [Google Scholar]
- Hantula, J.; Lilja, A.; Nuorteva, H.; Parikka, P.; Werres, S. Pathogenicity, morphology and genetic variation of Phytophthora cactorum from strawberry, apple, rhododendron, and silver birch. Mycol. Res. 2000, 104, 1062–1068. [Google Scholar] [CrossRef]
- Petróczy, M.; Palkovics, L. First report of Monilia polystroma on apple in Hungary. Eur. J. Plant Pathol. 2009, 125, 343–347. [Google Scholar] [CrossRef]
- Hibett, D.S. Ribosomal RNA and fungal systematics. Trans. Mycol. Soc. Jpn. 1992, 33, 533–556. [Google Scholar]
- Arzanlou, M.; Bakhshi, M. ITS-rDNA sequences differentiate a new lineage of Diplodia associated with canker disease of apple in Iran. Plant Pathol. Quar. 2012, 2, 132–141. [Google Scholar] [CrossRef]
- Diaz, G.A.; Mostert, L.; Halleen, F.; Lolas, M.; Gutierrez, M.; Ferrada, E.; Latorre, B.A. Diplodia seriata Associated with Botrypshaeria Canker and Dieback in Apples Trees in Chile. Plant Dis. 2019, 103, 1025. [Google Scholar] [CrossRef]
- McKean, P.G.; Vaughan, S.; Gull, K. The extended tubulin superfamily. J. Cell Sci. 2001, 114, 2723–2733. [Google Scholar] [CrossRef] [PubMed]
- Santos, L.; Phillips, A.J.L.; Crous, P.; Alves, A. Diaporthe species on Rosaceae with descriptions of D. pyracanthae sp. nov. and D. malorum sp. nov. Mycosphere 2017, 8, 485–511. [Google Scholar] [CrossRef]
- Pan, T.-T.; Xue, D.-S.; Li, B.-H.; Lian, S.; Wang, C.-X. Characterization of the pathogen causing shoot dieback on apple. Acta Phytopathol. Sinica 2020, 50, 107–111. [Google Scholar] [CrossRef]
- Li, H.; Zhang, Z.; Qin, G.; He, C.; Li, B.; Tian, S. Actin is required for cellular development and virulence of Botrytis cinerea via the mediation of secretory proteins. Msystems 2020, 5, e00732-19. [Google Scholar] [CrossRef]
- Tang, W.; Ding, Z.; Zhou, Z.Q.; Wang, Y.Z.; Guo, L.Y. Phylogenetic and pathogenic analyses show that the causal agent of apple ring rot in China is Botryosphaeria dothidea. Plant Dis. 2012, 96, 486–496. [Google Scholar] [CrossRef]
- Wennecker, M. Fungal Pathogens in Pome Fruit Orchards and Causal Agents of Postharvest Decay. Ph.D. Thesis, Wageningen University, Wageningen, The Netherlands, 25 February 2019; p. 200. [Google Scholar]
- Crous, P.W.; Slippers, B.; Wingfield, M.J.; Rheeder, J.; Marasas, W.F.O.; Phillips, A.; Alves, A.; Burgess, T.I.; Barber, P.A.; Groenewald, J.Z. Resolving phylogenetic lineages in the Botryosphaeriaceae. Stud. Mycol. 2006, 55, 235–253. [Google Scholar] [CrossRef]
- Udayanga, D.; Liu, X.Z.; Crous, P.W.; McKenzie, E.H.C.; Chukeatirote, E.; Hyde, K.D. A multi-locus phylogenetic evaluation of Diaporthe (Phomopsis). Fungal Divers. 2012, 56, 157–171. [Google Scholar] [CrossRef]
- Udayanga, D.; Castlebury, L.A.; Rossman, A.Y.; Chukeatirote, E.; Hyde, K.D. Insights into the genus Diaporthe: Phylogenetic species delimitation in the D. eres species complex. Fungal Divers. 2014, 67, 203–229. [Google Scholar] [CrossRef]
- Gomes, R.R.; Glienke, C.; Videira, S.I.R.; Lombard, L.; Groenewald, J.Z.; Crous, W. Diaporthe: A genus of endophitic, saprofitic and plant pathogenic fungi. Persoonia 2013, 31, 1–41. [Google Scholar] [CrossRef] [PubMed]
- Dissanayake, A.J.; Phillips, A.J.L.; Hyde, K.D.; Yan, J.Y.; Li, X.H. The current status of species in Diaporthe. Mycosphere 2017, 8, 1106–1156. [Google Scholar] [CrossRef]
- Gilbertson, R.L.; Ryvarden, L. North American Polypores Vol. 2: Megasporoporia–Wrightoporia; Fungiflora: Oslo, Norway, 1987; pp. 437–885. [Google Scholar]
- Ryvarden, L.; Gilbertson, R.L. European Polypores: Part 2: Meripilus–Tyromyces; Fungiflora: Oslo, Norway, 1994; pp. 394–743. [Google Scholar]
- Justo, A.; Hibbett, D.S. Phylogenetic classification of Trametes (Basidiomycota, Polyporales) based on a five-marker dataset. Taxon 2011, 60, 1567–1583. [Google Scholar] [CrossRef]
- Welti, S.; Moreau, P.-A.; Favel, A.; Courtecuisse, R.; Haon, M.; Navarro, D.; Taussac, S.; Lesage-Meessen, L. Molecular phylogeny of Trametes and related genera, and description of a new genus Leiotrametes. Fungal Divers. 2012, 55, 47–64. [Google Scholar] [CrossRef]
- Carlson, A.; Justo, A.; Hibbett, D.S. Species delimitation in Trametes: A comparison of ITS, RPB1, RPB2 and TEF1 Gene Phylogenies. Mycologia 2014, 106, 735–745. [Google Scholar] [CrossRef]
- Crous, P.W.; Summerell, B.A.; Swart, L.; Denman, S.; Taylor, J.E.; Beziudenhout, C.M.; Palm, M.E.; Mariconowitz, S.; Groenewald, J.Z. Fungal pathogens of Proteaceae. Persoonia 2011, 27, 20–45. [Google Scholar] [CrossRef]
- Maharachchikumbura, S.S.N.; Guo, L.-D.; Chukeatirote, E.; Bahkali, A.H.; Hyde, K.D. Pestalotiopsis—Morphology, phylogeny, biochemistry and diversity. Fungal Divers. 2011, 50, 167–187. [Google Scholar] [CrossRef]
- Maharachchikumbura, S.S.N.; Hyde, K.D.; Groenewald, J.Z.; Xu, J.; Crous, P.W. Pestalotiopsis revisited. Stud. Mycol. 2014, 79, 121–186. [Google Scholar] [CrossRef]
- Kanematsu, S.; Kobayashi, T.; Kudo, A.; Ohtsu, Y. Conidial morphology, pathogenicity and culture characteristics of Phomopsis isolates from peach, Japanese pear and apple in Japan. Jpn. J. Phytopathol. 1999, 65, 264–273. [Google Scholar] [CrossRef]
- Santos, J.M.; Phillips, A.J.L. Resolving the complex of Diaporthe (Phomopsis) species occurring on Feoniculum vulgare in Portugal. Fungal Divers. 2009, 34, 111–125. [Google Scholar]
- Van Niekerk, J.M.; Crous, P.W.; Groenewald, J.Z.; Fourie, P.H.; Halleen, F. DNA phylogeny, morphology and pathogenicity of Botryosphaeria species on grapevines. Mycologia 2004, 96, 781–798. [Google Scholar] [CrossRef] [PubMed]
- Van Niekerk, J.M.; Groenewald, J.Z.; Farr, D.F.; Fourie, P.H.; Halleen, F.; Crous, P.W. Reassessment of Phomopsis species on grapevine. Australas. Plant Pathol. 2005, 34, 27–39. [Google Scholar] [CrossRef]
- Koenraadt, S.; Somerville, S.C.; Jones, A.L. Characterization of mutations in the beta-tubulin gene of benomyl-resistant field strains of Venturia inequalis and other plant pathogenic fungi. Phytopathology 1992, 82, 1348–1354. [Google Scholar] [CrossRef]
- Begerow, D.; Beate, J.; Oberwinkler, F. Evolutionary relationships among β-tubulin gene sequences of basidiomycetous fungi. Mycol. Res. 2004, 108, 1257–1263. [Google Scholar] [CrossRef]
- Mang, S.M.; Scrano, L.; Camele, I. Preliminary studies on fungal contamination of two rupestrian churches from Matera (Southern Italy). Sustainability 2020, 12, 6988. [Google Scholar] [CrossRef]
- Hyde, K.D.; Dong, Y.; Phookamsak, R.; Jeewon, R.; Bhat, D.J.; Jones, E.B.; Liu, N.G.; Abeywickrama, P.D.; Mapook, A.; Wei, D.; et al. Fungal diversity notes 1151–1276: Taxonomic and phylogenetic contributions on genera and species of fungal taxa. Fungal Diver. 2020, 100, 5–277. [Google Scholar] [CrossRef]
- Mang, S.M.; Raciopi, R.; Camele, I.; Rana, G.L.; D’Auria, M. Use of metabolic profiles to distinguish three Monilinia species. Plant Ptahol. 2015, 97, 55–59. [Google Scholar] [CrossRef]
- Sofo, A.; Elshafie, H.S.; Scopa, A.; Mang, S.M.; Camele, I. Impact of airborne zinc polution on the antimicrobial activity of olive oil and teh microbial metabolic profiles of Z-contaminated soils in an Italian olive orchard. J. Trace Elem. Med. Biol. 2018, 49, 276–284. [Google Scholar] [CrossRef]
- Hofstetter, V.; Buyck, B.; Eyssartier, G.; Schnee, S.; Gindro, K. The unabearable lightness of sequence-based identification. Fungal Diver. 2019, 96, 243–284. [Google Scholar] [CrossRef]
- Senanayake, I.C.; Jeewon, R.; Chomnunti, P.; Wanasinghe, D.N.; Norphanphoun, C.; Karunarathna, A.; Pem, D.; Perera, R.H.; Camporesi, E.; McKenzie, E.H.; et al. Taxonomic circumscription of Diaporthales based on multigene phylogeny and morphology. Fungal Divers. 2018, 93, 241–443. [Google Scholar] [CrossRef]
- Senanayake, I.C.; Rathnayaka, A.R.; Marasinghe, D.S.; Calabon, M.S.; Gentekaki, E.; Lee, H.B.; Hurdeal, V.G.; Pem, D.; Dissanayake, L.S.; Wijesinghe, S.N.; et al. Morphological approaches in studying fungi: Collection, examination, isolation, sporulation and preservation. Mycosphere 2020, 11, 2678–2754. [Google Scholar] [CrossRef]
- Wibberg, D.; Stadler, M.; Lambert, C.; Bunk, B.; Spröer, C.; Rückert, C.; Kalinowski, J.; Cox, R.J.; Kuhnert, E. High quality genome sequences of thirteen Hypoxylaceae (Ascomycota) strengthen the phylogenetic family backbone and enable the discovery of new taxa. Fungal Divers. 2021, 106, 7–28. [Google Scholar] [CrossRef]
- Vu, D.; Groenewald, M.; de Vries, M.; Gehrmann, T.; Stielow, B.; Eberhardt, U.; Al-Hatmi, A.; Groenewald, J.Z.; Cardinali, G.; Houbraken, J.; et al. Large-scale generation and analysis of filamentous fungal DNA barcodes boosts coverage for kingdom fungi and reveals thresholds for fungal species and higher taxon delimitation Stud. Mycol. 2019, 92, 135–154. [Google Scholar] [CrossRef]
- Schoch, C.L.; Seifert, K.A.; Huhndorf, S.; Robert, V.; Spouge, J.L.; Levesque, C.A.; Chen, W.; Fungal Barcoding Consortium; Fungal Barcoding Consortium Author List; Bolchacova, E. Nuclear ribosomal internal transcribed spacer (ITS) region as a universal DNA barcode marker for Fungi. Proc. Natl. Acad. Sci. USA 2012, 109, 6241–6246. [Google Scholar] [CrossRef]
- Kiss, L. Limits of nuclear ribosomal DNA internal transcribed spacer (ITS) sequences as species barcode for fungi. Proc. Natl. Acad. Sci. USA 2012, 109, E1811. [Google Scholar] [CrossRef]
- Xiao, C.L.; Boal, R.J. A New Canker and Twig Dieback Disease of Apple and Crabapple Trees Caused by Sphaeropsis pyriputrescens in Washington State. Plant Dis. 2005, 89, 10. [Google Scholar] [CrossRef]
- Jabiri, S.; Lahlali, R.; Bahra, C.; Amraoui, M.B.; Tahiri, A.; Amiri, S. First report of Phytopythium vexans associated with dieback disease of apple trees in Morocco. J. Plant Pathol. 2020, 102, 1319. [Google Scholar] [CrossRef]
- Bai, Q.; Zhai, L.F.; Chen, X.R.; Hong, N.X.; Xu, W.X.; Wang, G.P. Biological and molecular characterization of five Phomopsis species associated with pear shoot canker in China. Plant Dis. 2015, 99, 1704–1712. Available online: http://apsjournals.apsnet.org/loi/pdis (accessed on 18 January 2021). [CrossRef]
- Bertetti, D.; Guarnaccia, V.; Spadaro, D.; Gullino, M. First report of fruit rot caused by Diaporthe eres Nitschkle on European pear cultivated in Italy. (Diaporthe eres Nitschkle, agente di marciume su frutti di pero in Italia). Prot. Delle Colt. 2018, 5, 10–13. [Google Scholar] [CrossRef]
- Dissanayake, A.J.; Camporesi, E.; Hyde, K.D.; Zhang, W.; Yan, J.Y.; Li, X.H. Molecular phylogenetic analysis reveals seven new Diaporthe species from Italy. Mycosphere 2017, 8, 853–877. [Google Scholar] [CrossRef]
- Ali, S.; Renderos, W.; Bevis, E.; Hebb, J.; Abassi, P.A. Diaporthe eres causes stem cankers and death of young apple rootstocks in Canada. Can. J. Plant Pathol. 2020, 42, 217–227. [Google Scholar] [CrossRef]
- Florian, V.C.; Puia, C.; Groza, R.; Suciu, L.A.; Florian, T. Study of the major pathogens that lead to apple fruit decay during storage. Not. Bot. Horti Agrobot. Cluj-Napoca 2018, 46, 538–545. [Google Scholar] [CrossRef]
- Sun, W.; Huang, S.; Xia, J.; Zhang, X.; Li, Z. Morphological and molecular identification of Diaporthe species in south-western China, with description of eight new species. MycoKeys 2021, 77, 65–95. [Google Scholar] [CrossRef]
- Abramczyk, B.; Król, E.D.; Zalewska, E.D.; Zimowska, B. Morphological characteristics and pathogenicity of Diaporthe eres isolates to the fruit tree shoots. Acta Sci. Pol. -Hortorum Cultus 2018, 17, 125–133. [Google Scholar] [CrossRef]
- Chaisiri, C.; Liu, X.; Lin, Y.; Fu, Y.; Zhu, F.; Luo, C. Phylogenetic and Haplotype Network Analyses of Diaporthe eres Species in China Based on Sequences of Multiple Loci. Biology 2021, 10, 179. [Google Scholar] [CrossRef]
- Sessa, L.; Abreo, E.; Bettucci, L.; Lupo, S. Diversity and virulence of Diaporthe species associated with wood diseases symptoms in deciduous fruit trees in Uruguay. Phytopathol. Mediterr. 2017, 56, 431–444. [Google Scholar] [CrossRef]
- Thompson, S.M.; Tan, Y.P.; Young, A.J.; Neate, S.M.; Aitken, E.A.B.; Shivas, R.G. Stem cankers on sunflower (Helianthus annuus) in Australia reveal a complex of pathogenic Diaporthe (Phomopsis) species. Pers. Molec. Phylogen. Evol. Fungi 2011, 27, 80–89. [Google Scholar] [CrossRef]
- Slippers, B.; Smit, W.A.; Crous, P.W.; Countinho, T.A.; Wingfield, B.D.; Wingfield, M.J. Taxonomy, phylogeny and identification of Botryosphaeriaceace associated with pome and stone fruit trees in South Africa and other regions of the world. Plant Pathol. 2007, 56, 128–139. [Google Scholar] [CrossRef]
- Yu, Z.D.; Tang, G.H.; Peng, S.B.; Chen, H.; Zhai, M.Z. Neofusicoccum parvum causing canker of seedlings of Juglans regia in China. J. For. Res. 2015, 26, 1019–1024. [Google Scholar] [CrossRef]
- Shen, Y.-M.; Chao, C.-H.; Liu, H.L. First Report of Neofusicoccum parvum Associated with Stem Canker and Dieback of Asian Pear Trees in Taiwan. Plant Dis. 2010, 94, 1062. [Google Scholar] [CrossRef] [PubMed]
- Choi, S.; Paul, N.C.; Lee, K.-H.; Kim, H.-J.; Sang, H. Morphology, Molecular Phylogeny, and Pathogenicity of Neofusicoccum parvum, Associated with Leaf Spot Disease of a New Host, the Japanese Bay Tree (Machilus thunbergii). Forests 2021, 12, 440. [Google Scholar] [CrossRef]
- Zmitrovich, I.V.; Ezhov, O.N.; Wasser, S.P. A survey of species of genus Trametes Fr. (higher basidiomycetes) with estimation of their medicinal source potential. Int. J. Med. Mushrooms 2012, 14, 307–319. [Google Scholar] [CrossRef]
- Habtermariam, S. Trametes versicolor (Synn. Coriolus versicolor) Polysaccharides in Cancer Therapy: Targets and Efficiency. Biomedicines 2020, 8, 135. [Google Scholar] [CrossRef]
- Pop, R.M.; Puia, I.C.; Puia, A.; Chedea, V.S.; Leopold, N.; Bocsan, I.C.; Buzoianu, A.D. Characterization of Trametes versicolor: Medicinal Mushroom with Important Health Benefits. Not. Bot. Horti Agrobot. Cluj-Napoca 2018, 46, 343–349. [Google Scholar] [CrossRef]
- Kile, G. The Host-Pathogen Relationship between Apple and Trametes versicolor and Factors Affecting Host Susceptibility. Ph.D. Thesis, University of Tasmania, Hobart, Australia, 1971. [Google Scholar]
- Darbyshire, B. Factors Influencing the Susceptibility of Apple Trees to Trametes (Polystictus) versicolor. Ph.D. Thesis, University of Tasmania, Hobart, Australia, 1968. [Google Scholar]
- Dilley, M.A.; Covey, R.P., Jr. Association of Coriolus versicolor with a dieback disease of apples in Washington State. Plant Dis. 1981, 85, 77–78. [Google Scholar] [CrossRef]
- Udayanga, D.; Liu, X.Z.; McKenzie, E.H.C.; Chukeatirote, E.; Bahkali, A.H.A.; Hyde, L.D. The genus Phomopsis: Biology, applications, species concepts and names of common phytopathogens. Fungal Divers. 2011, 50, 189–225. [Google Scholar] [CrossRef]
- Karaoglanidi, G.; Bardas, G. First Report of Phomopsis Fruit Decay on Apple Caused by Phomopsis mali in Greece. Plant Dis. 2006, 90, 375. [Google Scholar] [CrossRef]
- Abramczyk, B.; Król, E. Use of RAPD-PCR and its markers for identification of Diaporthe/Phomopsis from fruit trees in south-eastern Poland. Acta Sci. Pol. -Hortorum Cultus 2016, 15, 161–175. Available online: http://ww.acta.media.pl/pl/action/getfullphp?id=5213 (accessed on 8 January 2020).
- Pertot, I.; Vindimian, M.E. Diffusione di Phomopsis mali, agente di moria in giovani impianti di melo in Trentino. Inform. Fitopatol. 1998, 48, 45–49. Available online: http://hdl.handle.net/10449/17658 (accessed on 8 January 2020).
- Espinoza, J.G.; Briceño, E.X.; Chávez, E.R.; Úrbez-Torrez, J.R.; Latorre, B.A. Neofusicoccum spp. Associated with Stem Canker and Dieback of Blueberry in Chile. Plant Dis. 2009, 93, 1187–1194. [Google Scholar] [CrossRef] [PubMed]
- Schaad, N.W.; Jones, J.B.; Chun, W. Laboratory Guide for the Identification of Plant Pathogenic Bacteria, 3rd ed.; The American Phytopathological Society: St. Paul, MN, USA, 2001; 373p. [Google Scholar]
- White, T.J.; Bruns, T.; Lee, S.; Taylor, J. Amplified and direct sequencing of fungal ribosomal RNA genes for phylogenetics. In PCR Protocols: A Guide to Methods and Applications; Innis, M.A., Gelfand, D.H., Sninsky, J.J., White, T.J., Eds.; Academic: San Diego, CA, USA, 1990; pp. 315–322. [Google Scholar]
- Glass, N.L.; Donaldson, G.C. Development of primer sets designed for use with the PCR to amplify conserved genes from filamentous ascomycetes. Appl. Environ. Microbiol. 1995, 61, 1323–1330. [Google Scholar] [CrossRef] [PubMed]
- Cabone, I.; Kohn, L.M. A method for designing primer sets for speciation studies in filamentous ascomycetes. Mycologia 1999, 91, 553–556. [Google Scholar] [CrossRef]
- Mang, S.M.; Bonomo, M.G.; Camele, I.; Saturnino, C.; Capasso, A.; Salzano, G. Preliminary Investigation of Allergenic Fungi in an Indoor Environment. Pharmacologyonline 2020, 2, 314–320. [Google Scholar]
- Altschul, S.F.; Gish, W.; Miller, W.; Myers, E.W.; Lipman, J.D. Basic Local Alignment Search Tool. J. Mol. Biol. 1990, 215, 403–410. [Google Scholar] [CrossRef]
- Johnson, M.; Zaretskaya, I.; Raytselis, Y.; Merezhuk, Y.; Mcginnis, S.; Madden, T.L. NCBI BLAST: A better web interface. Nucl. Acids Res. 2008, 36 (Suppl. 2), W5–W9. [Google Scholar] [CrossRef] [PubMed]
- Larkin, M.A.; Blackshields, G.; Brown, N.P.; Chenna, R.; McGettigan, P.A.; McWilliam, H.; Valentin, F.; Wallace, I.M.; Wilm, A.; Lopez, R.; et al. Clustal W and Clustal X version 2.0. Bioinformatics 2007, 23, 2947–2948. [Google Scholar] [CrossRef]
- Kumar, S.; Stecher, G.; Li, M.; Knyaz, C.; Tamura, K. MEGA X: Molecular Evolutionary Genetic Analysis across computing platforms. Molec. Biol. Evol. 2018, 35, 1547–1549. [Google Scholar] [CrossRef]
- Saitou, N.; Nei, M. The neighbor-joining method: A new method for reconstructing phylogenetic trees. Mol. Biol. Evol. 1987, 4, 406–425. [Google Scholar] [CrossRef]
- Felsenstein, J. Confidence intervals on phylogenetics: An approach using bootstrap. Evolution 1985, 39, 783–791. [Google Scholar] [CrossRef]
- Dopazo, J. Estimating errors and confidence intervals for branch lengths in phylogenetic trees by a bootstrap approach. J. Mol. Evol. 1994, 38, 300–304. [Google Scholar] [CrossRef] [PubMed]
- Tajima, F.; Nei, M. Estimation of evolutionary distance between nucleotide sequences. Mol. Biol. Evol. 1984, 1, 269–285. [Google Scholar] [PubMed]
- Shapiro, S.S.; Wilk, M.B. An analysis of variance test for normality (complete samples). Biometrika 1965, 52, 591–611. [Google Scholar] [CrossRef]
- Holm, S. A simple sequentially rejective multiple test procedure. Scand. J. Stat. 1979, 6, 65–70. [Google Scholar]
- R Core Team. R: A Language and Environment for Statistical Computing, 2019; R Foundation for Statistical Computing: Vienna, Austria; Available online: https://www.R-project.org/ (accessed on 15 January 2022).

| Isolate Name | Species | GenBank Accession Number * | Identity (%) * | ||||
|---|---|---|---|---|---|---|---|
| ITS ** | TUB-2 ** | ACT ** | ITS ** | TUB-2 ** | ACT ** | ||
| Noefp1 | Neofusicoccum parvum | LR757960 | OU022063 | OU023206 | >99–100 | >99 | 100 |
| Neofp2 | N. parvum | LR757961 | OU022064 | OU023207 | -//- | -//- | -//- |
| Neofp3 | N. parvum | LR757962 | OU022065 | OU023208 | -//- | -//- | -//- |
| Neofp4 | N. parvum | LR757963 | OU022066 | OU023209 | -//- | -//- | -//- |
| Neofp5 | N. parvum | LR757964 | OU022067 | OU023210 | -//- | -//- | -//- |
| Neofp6 | N. parvum | LR757965 | OU022068 | OU023211 | -//- | -//- | -//- |
| Neofp7 | N. parvum | LR757966 | OU022069 | OU023212 | -//- | -//- | -//- |
| Tramtv1 | Trametes versicolor | LR759930 | - | - | >99–100 | - | - |
| Tramtv2 | T. versicolor | LR759931 | - | - | -//- | - | - |
| Tramtv3 | T. versicolor | LR759932 | - | - | -//- | - | - |
| Tramtv4 | T. versicolor | LR759933 | - | - | -//- | - | - |
| Tramtv5 | T. versicolor | LR759934 | - | - | -//- | - | - |
| Tramtv6 | T. versicolor | LR759935 | - | - | -//- | - | - |
| Diapore1 | Diaporthe eres | OU020696 | OU022056 | OU023199 | >99 | >99–100 | >99 |
| Diapore2 | D. eres | OU020697 | OU022057 | OU023200 | -//- | -//- | -//- |
| Diapore3 | D. eres | OU020698 | OU022058 | OU023201 | -//- | -//- | -//- |
| Diapore4 | D. eres | OU020699 | OU022059 | OU023202 | -//- | -//- | -//- |
| Diaporf1 | Diaporthe foeniculina | OU020700 | OU022060 | OU023203 | >99–100 | 100 | >99 |
| Diaporf2 | D. foeniculina | OU020701 | OU022061 | OU023204 | -//- | -//- | -//- |
| Diaporf3 | D. foeniculina | OU020702 | OU022062 | OU023205 | -//- | -//- | -//- |
| Pestf1 | Pestalotiopsis funerea | OU020703 | OU022070 | - | >99 | >99 | - |
| Pestf2 | P. funerea | OU020704 | OU022071 | - | -//- | -//- | - |
| Pestf3 | P. funerea | OU020705 | OU022072 | - | -//- | -//- | - |
| Phomp1 | Phomopsis sp. | OU026160 | - | - | >99 | - | - |
| Phomp2 | Phomopsis sp. | OU026161 | - | - | -//- | - | - |
| Phomp3 | Phomopsis sp. | OU026162 | - | - | -//- | - | - |
| Locus * | Primer | Sequences 5′→3′ | Reference |
|---|---|---|---|
| ITS | ITS5 | 5′-GGA AGT AAA AGT CGT AAC AAG G-3′ | White et al., 1990 |
| ITS4 | 5′-TCC TCC GCT TAT TGA TAT GC-3′ | ||
| TUB-2 | Bt2a | 5′-GGT AAC CAA ATC GGT GCT GCT TTC-3′ | Glass and Donaldson, 1995 |
| Bt2b | 5′-ACC CTC AGT GTA GTG ACC CTT GGC-3′ | ||
| ACT | ACT-512F | 5′-ATG TGC AAG GCC GGT TTC GC-3′ | Carbone and Kohn, 1999 |
| ACT-783R | 5′-TAC GAG TCC TTC TGG CCC AT-3′ |
| Taxa | Isolate Name | Culture No. | Gene | GenBank Accession Number * | Reference | ||
|---|---|---|---|---|---|---|---|
| ITS | TUB-2 | ACT | ITS | TUB-2 | ACT | ||
| Diaporthe eres | CBS 186.37 | CPC 30116 | CBS:145040 | MH855881 | MG281261 | MK442634 | Wu et al., 2019 |
| D. eres | SS48 | NEFF 3-23-4 | Pho12 | KP903620 | MW208555 | JN230370 | GenBank |
| D. eres | STEU 8322 | DB14AGO27 | MIFCC 316 | KY312645 | MH063919 | MN136112 | GenBank |
| D. eres | STEU 8323 | Nc1 | CBS:587.79 | KY312646 | LC316667 | KJ420770 | GenBank |
| D. eres | Fi2333 | MJL13 | DNP128 | KR023623 | MT109632 | KJ420762 | GenBank |
| Diaporthe foeniculina | ISPaVe 2156 | ColPat-560 | ISPaVe 2156 | LN651172 | MK522116 | LN651174 | GenBank a Lopez-Moral et al., 2020 |
| D. foeniculina | A1907B | Av-1 | ISPaVe 2157 | MT230444 | MT374093 | LN651175 | GenBank c Udayanga et al., 2014 |
| D. foeniculina | P101b | CAA133 | MEP12891 | MT735646 | KY435665 | KC843283 | GenBank a Mathioudakis et al., 2020 c Udayanga et al., 2014 |
| ** Diaporthella corylina | CBS121124 | CBS121124 | CBS:592.81 | KC343004 | KC343972 | N/A | Gomes et al., 2013 |
| ** Diaporthe helianthi | N/A | N/A | AR4131 | N/A | N/A | KF199885 | c GenBank |
| Neofusicoccum parvum | B32 | ACBA15 | YELO-21a | KJ499738 | MG970291 | MH393619 | GenBank |
| N. parvum | B65 | AKKA308.2 | CMW 7773 | KJ499740 | MH221123 | - e | GenBank c Hunter et al.,2006 |
| d N. ribis | - e | - e | CMW 7773 | - e | - e | DQ267605 | GenBank |
| N. parvum | B135 | 11215_3 | N/A | KJ499742 | JX398944 | N/A | GenBank |
| N. parvum | B146 | MFLUCC_12-0380 | N/A | KJ499743 | MN643160 | N/A | GenBank |
| N. parvum | Fi2326 | GDTCMF23 | N/A | KR002830 | MT424811 | N/A | GenBank |
| N. parvum | JRad16 | CBS:130994 | N/A | KY680281 | a MT529709 | N/A | GenBank a Zhang et al., 2021 |
| N. parvum | CMW9081; ICMP 8003 | CMW994 | N/A | NR119487 | a AY236912 | N/A | GenBank a Slippers et al., 2004 |
| ** Diplodia seriata | ASJ297 | HL1 | N/A | MH221102 | JF4040814 | N/A | GenBank |
| b Botryosphaeria dothidea | N/A | N/A | HPLW1 | N/A | N/A | JF440940 | a Tang et al., 2012 |
| Pestalotiopsis funerea | ML4DY | ML4DY | N/A | EF055197 | EF055234 | N/A | GenBank |
| Pestalotiopsis sp. | SGSGf16 | TAP18N030 | N/A | EU715650 | LC427211 | N/A | GenBank |
| Pestalotiopsis sp. | ZC-W-1-1 | BRIP 66615 | N/A | KR822153 | MK977634 | N/A | GenBank |
| Pestalotiopsis sp. | NW-FWA2867 | ZX18A | N/A | MG098325 | MW218534 | N/A | GenBank |
| ** Sordaria alcina | CBS 109460 | CBS 109460 | N/A | AY681198 | a AY681232 | N/A | Liu et al., 2010 a Cai et al., 2006 |
| Phomopsis sp. | FN-1-N1-2-2 | N/A | N/A | KJ465317 | N/A | N/A | GenBank |
| Phomopsis sp. | blx-2-51 | N/A | N/A | MN944543 | N/A | N/A | GenBank |
| Phomopsis sp. | Peach | N/A | N/A | MK934328 | N/A | N/A | GenBank |
| Phomopsis sp. | 136.1-COLP-L | N/A | N/A | KT182885 | N/A | N/A | GenBank |
| **Valsa japonica | CBS375.29 | N/A | N/A | AF191185 | N/A | N/A | Adams et al., 2002 |
| Trametes versicolor | D. HaelewF-1599pt.2a | N/A | N/A | MN749366 | N/A | N/A | GenBank |
| T. versicolor | STEU 8295 | N/A | N/A | KY312629 | N/A | N/A | GenBank |
| T. versicolor | STEU 8296 | N/A | N/A | KY312630 | N/A | N/A | GenBank |
| T. versicolor | 2473 | N/A | N/A | AM269814 | N/A | N/A | GenBank |
| ** Grifola frondosa | WC835 | N/A | N/A | AY049140 | N/A | N/A | Shen et al., 2002 |
Publisher’s Note: MDPI stays neutral with regard to jurisdictional claims in published maps and institutional affiliations. |
© 2022 by the authors. Licensee MDPI, Basel, Switzerland. This article is an open access article distributed under the terms and conditions of the Creative Commons Attribution (CC BY) license (https://creativecommons.org/licenses/by/4.0/).
Share and Cite
Mang, S.M.; Marcone, C.; Maxim, A.; Camele, I. Investigations on Fungi Isolated from Apple Trees with Die-Back Symptoms from Basilicata Region (Southern Italy). Plants 2022, 11, 1374. https://doi.org/10.3390/plants11101374
Mang SM, Marcone C, Maxim A, Camele I. Investigations on Fungi Isolated from Apple Trees with Die-Back Symptoms from Basilicata Region (Southern Italy). Plants. 2022; 11(10):1374. https://doi.org/10.3390/plants11101374
Chicago/Turabian StyleMang, Stefania Mirela, Carmine Marcone, Aurel Maxim, and Ippolito Camele. 2022. "Investigations on Fungi Isolated from Apple Trees with Die-Back Symptoms from Basilicata Region (Southern Italy)" Plants 11, no. 10: 1374. https://doi.org/10.3390/plants11101374
APA StyleMang, S. M., Marcone, C., Maxim, A., & Camele, I. (2022). Investigations on Fungi Isolated from Apple Trees with Die-Back Symptoms from Basilicata Region (Southern Italy). Plants, 11(10), 1374. https://doi.org/10.3390/plants11101374
